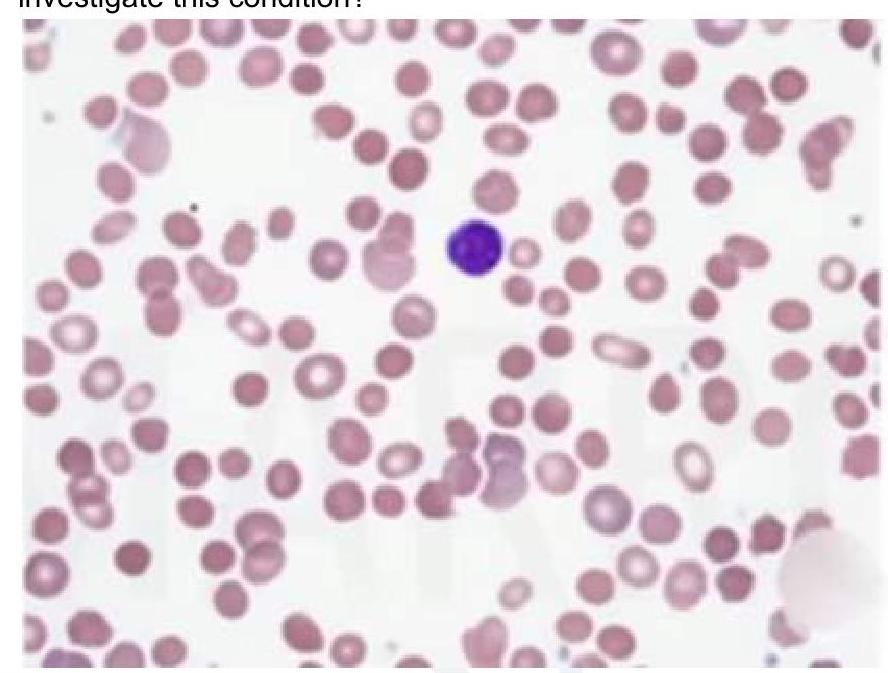
Image for question 5

Enter your email to get your 85% OFF code and unlock the full NEET PG question bank on the app.
Hemolysis is predominantly intravascular in which of the following conditions?
An adult female presents with pallor and fatigue. Blood investigations show low hemoglobin ( Hb ), low serum iron, low ferritin, low transferrin saturation, and increased total iron-binding capacity (TIBC). What is the likely diagnosis?
Which of the following causes aplastic crisis in hereditary spherocytosis?
Which of the following conditions is the classic example of acute intravascular hemolysis triggered by oxidative stress?
A child presents with intermittent jaundice and splenomegaly. There is a history of similar complaints in the elder brother. Peripheral smear shows the following finding. What is the most appropriate investigation for this condition?
A previously healthy child has sudden onset of red spots on body. There is a history of a preceding viral infection 1-4 weeks before the onset.
A 7-year-old boy presents with a palpable, non-blanching rash that started 3 days prior and involves the lower limbs and buttocks, following a previous viral upper respiratory tract infection. His blood pressure is normal, and kidney function tests are normal. What is the diagnosis?
Which of the following is not a characteristic of Fanconi's anemia?
A baby born at 34 weeks gestation weighs 3kg. Which of the following conditions is this child most likely to develop in the immediate postnatal period?
A 3-year-old child was brought to the emergency room with complaints of hematuria after accidental ingestion of naphthalene balls, which indicates:
Get full access to all questions, explanations, and performance tracking.
Scan to download app